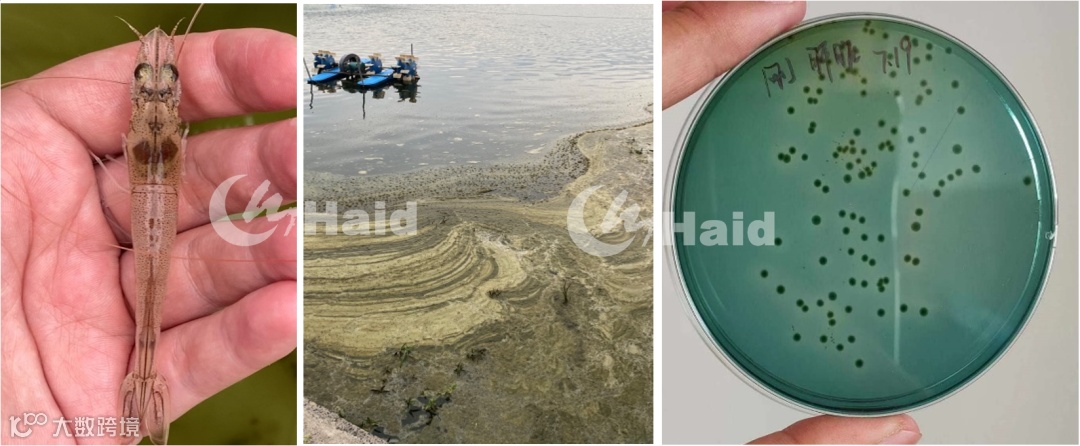
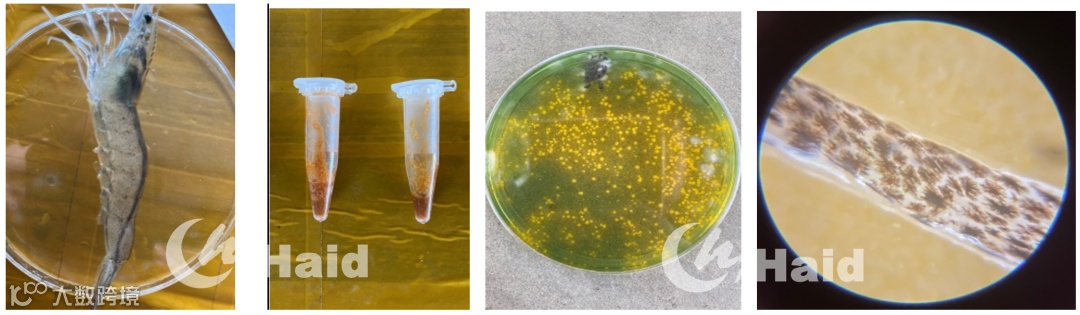

文 | 图 浙江海大 黄涛 张鹏
加餐宝采用“先发酵后制粒”的低温工艺,充分保留益生菌及其发酵产物的生物活性。
一、浙江外塘白虾,3-4成发病率
2021年7月5日浙江正式出梅,相对于去年长达50天的漫长煎熬,今年的梅雨期整整缩短了一半,让不少养户紧绷的神经有了些许放松。梅雨期池塘水质不稳定、虾子应激大,通常养户会刻意控料,减少消化负担,降低发病几率。虽然梅雨期已经结束,但紧接着长达2个月的高温期也是路阻且长。
按照以往的经验,梅雨转高温往往容易出现慢料空肠,白便偷死等种种问题,今年也不例外。截至目前,浙江外塘白虾预计3-4成发病率。

二、高温时,出现肠炎主要有原因
很多养户说前几年出现肠炎,用点药就明显好转,这两年发现尽管使用了许多药物,可还是一点效果都没有,这到底什么原因?首先,引起肠炎的原因是复杂多样的,这也就解释了为什么方案有时候不起作用,究其原因是没找到对虾发病的真正原因。
我们将经过总结后,发现高温时出现肠炎主要有几点原因:
左一:空肠、肝脏萎缩 左二:水浓死藻多 左三:弧菌超标
三、有一批客户
他们基本上没有遇到过肠炎白便等问题
出现肠炎慢料问题,大家更多的是期待药品能够精准处理肠炎白便,但是事与愿违。正是因为较为复杂的发病机理,导致市面上很难找到100%处理肠炎白便的神药。当多数客户对高温慢料一筹莫展时,海大技术团队对优质户进行挖宝调研,惊喜发现市场上仍然有一批客户,基本上没有遇到过肠炎白便等问题。通过交流发现他们普遍认同防重于治的理念,总结他们对于肠炎问题的处理思路,发现他们在水体补菌,活菌拌料等几个关键点上高度相似。

韩老板外塘面积200多亩,养殖10多年几乎很少遇到肠炎及白便问题,他提到关键秘诀之一就是内外兼修,5天使用一次虾多宝发酵液泼水,同时每天坚持拌喂活菌。
这样做最大的好处就是肠道粗,减少对虾消化负担,还能起到一定的调水作用。但他也提到拌料操作复杂,费时费力,使用较为不便。
四、加餐宝
每一口都富含益生菌群和益生元
我们发现一方面客户很认可活菌发酵型产品,不过又觉得自制发酵饲料复杂,使用不便。就在今年,海大集团推出了新款功能软颗粒——加餐宝,工艺优势明显,使用便捷简单,上市后受到了很多客户的热烈欢迎,究竟加餐宝有哪些神奇之处呢?

全芯发酵,稳定性好
市面上的发酵料基本都是商品料的基础上外喷菌液,这也意味着发酵产物只存在饲料表层,且容易出现涨袋或霉变,投入水体中溃散率高,被对虾吸收的少。加餐宝将有益菌及其发酵产物、天然中草药提取物、功能性营养物质等充分混合,再经先进的低温工艺技术,使得每一颗产品都“表里如一”,确保对虾每一口食物都富含益生菌群和益生元!
加餐宝耐水能达8小时,泡水后碾碎,放在显微镜下看到满满的都是活菌。其他产品长时间泡水后溃散明显,水质较差,加餐宝组水质更为清爽,有效成分不溶失,不仅不会污染水质,还因富含益生菌而协同稳水。


诱食性强,开胃绝佳
作为一款高档功能性软颗粒,加餐宝精选优质的深海鱼粉,并复配多种独特的发酵原料,诱食性及适口性绝佳,能够快速吸引对虾聚群摄食。同时,加餐宝进入对虾体内后会释放大量的天然消化酶和多元有机酸,进一步提升对虾的摄食欲望,对虾吃得更多,长得更快。
为了探究加餐宝的适口性,我们在料台上放入半斤加餐宝,发现12分钟时已经吸引大批虾子采食,25分钟全部吃完,且粪便紧实短小。

促进提料,修复肠道损伤
案例1:萧山赵老板
第3天吃料加快,第5天逐渐加料!
萧山赵老板,15亩外塘5月8日放苗70万,6月21日早上喂料30斤3小时吃不完,抛网发现有少量空肠现象,镜检肠道色素明显扩散。客户按10%比例使用加餐宝拌喂,每天2餐。结合调水补菌方案,第3天吃料加快,第5天开始逐渐加料。
使用前

左一:水质偏瘦 左二:少量空肠 左三:3级肠道
使用后

左一:水质肥嫩 左二:肠道饱满、白膜清晰 左三:2级肠道

案例2:萧山俞老板
使用前1周加不上料,
使用后几天后料逐渐加到30斤!
萧山俞老板,5亩外塘5月1日放苗20万,养殖50天控料1个半小时只能吃25斤,1周加不上料,肝脏研磨偏黄处于亚健康,检测弧菌超标,肠道色素扩散。客户使用加餐宝拌料,结合水体消毒,几天后料逐渐加到30斤,肝脏研磨鲜红,弧菌明显减少,镜检肠道健康。
使用前
左一:麻点多 左二:肝脏研磨黄 左三:肝脏弧菌多 左四:3级肠道
使用后

左一:麻点少 左二:肝脏研磨红 左三:肝脏弧菌少 左四:1级肠道
除了上述客户外,我们还统计了30多位正在使用加餐宝的客户,多数使用前存在不同程度慢料,使用加餐宝一段时间后:
(1)摄食速度明显提快,平均时间由120.5分钟缩短到103.5分钟,加快17分钟。
(2)吃料量上有明显的改变,使用前平均投喂量25.3斤/餐,常规加料组1周后投喂量39.5斤左右,而使用加餐宝的客户吃料明显好于正常加料组,可以达到45.4斤。
此外针对肠道色素的修复,加餐宝也有着不错的效果,使用前肠道色素多数处于3级,坚持使用肠道色素明显改善,一级和二级肠道的比例从21%增加到58%。



四、总 结
浙江区域的梅雨及高温气候容易引发水质波动、底质恶化、弧菌爆发等一系列问题,从而导致对虾出现肠炎慢料和空肠白便。做好水质调控的同时,更为关键的是健肠促消化,增强虾体自身免疫功能。
加餐宝采用“先发酵后制粒”的低温工艺,充分保留益生菌及其发酵产物的生物活性。进入虾体后,提高消化吸收能力,减轻肠道负担,越来越多的客户选择使用加餐宝。使用后,大家都感觉虾子吃料时间加快,在改善慢料问题发挥极为明显作用,毫无疑问,加餐宝是高温预防肠炎的明智之选。
海大农牧
接地气的水产一线技术
长摁二维码,即刻关注






